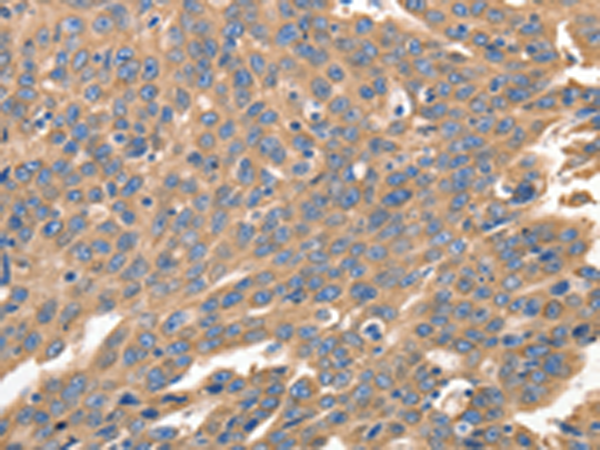

-
分类: 科研抗体货号: P03994别名: GLUT3应用: WB,IHC反应种属: Human
-
分类: 科研抗体货号: P03997别名: GLUT10, GLUT11, SLC2A11-a, SLC2A11-c应用: IHC反应种属: Human
-
分类: 科研抗体货号: P04050别名: MAR, IRF-1应用: WB,IHC反应种属: Human, Mouse, Rat
-
分类: 科研抗体货号: P03987别名: GDNFR3应用: WB,IHC反应种属: Human, Mouse
-
分类: 科研抗体货号: P04045别名: p55; CD25; IL2R; IMD41; TCGFR; IDDM10应用: WB反应种属: Human, Mouse, Rat
-
分类: 科研抗体货号: P03985别名: GDNFR; RET1L; RETL1; TRNR1; GDNFRA; GFR-ALPHA-1应用: WB,IHC反应种属: Human, Mouse, Rat
-
分类: 科研抗体货号: P04037别名: HECH; HP1-GAMMA; HP1Hs-gamma应用: WB,IHC反应种属: Human, Mouse
-
分类: 科研抗体货号: P03982别名: DORV, DTGA3应用: WB反应种属: Human, Mouse
-
分类: 科研抗体货号: P04035别名: Hox-4.6, Hoxd-11应用: WB反应种属: Human, Mouse
-
分类: 科研抗体货号: P04072别名: CGB4; HH23; LSH-B; LSH-beta应用: WB,IHC反应种属: Human, Mouse

鄂公网安备42018502007531号
鄂公网安备42018502007531号

